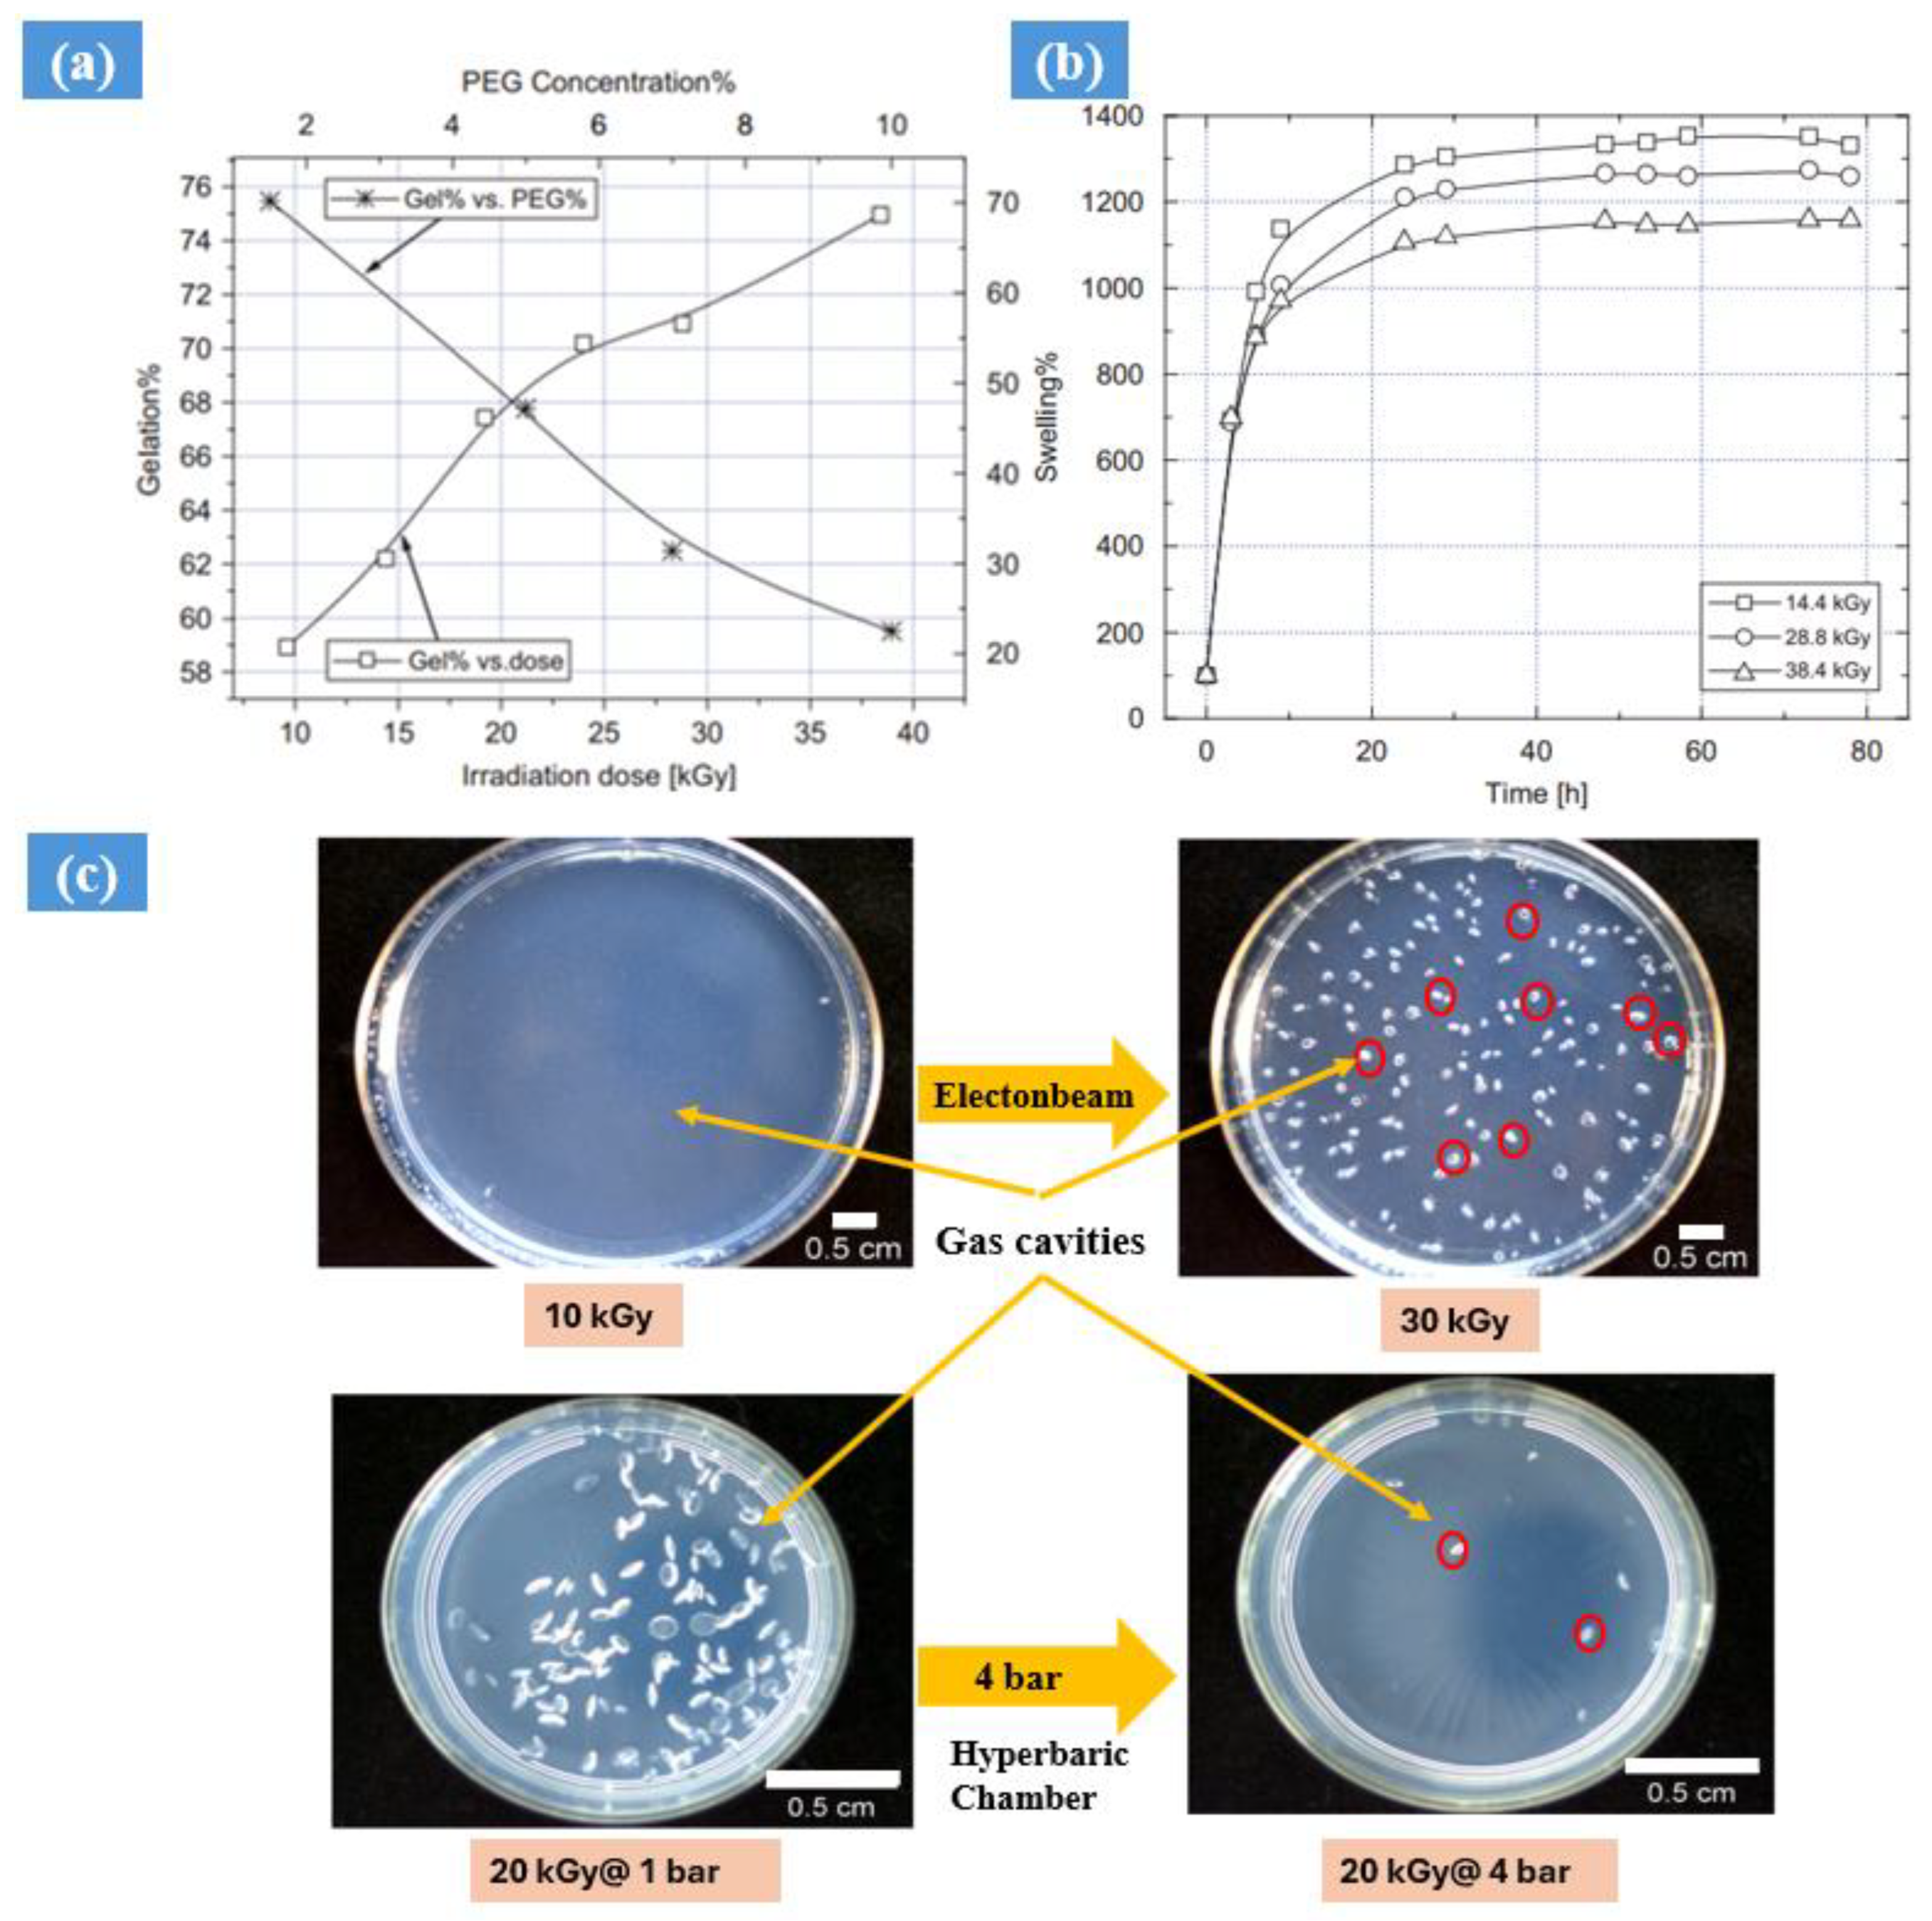
Gels 10 00381 g006

A Comprehensive Review of Radiation-Induced Hydrogels: Synthesis, Properties, and Multidimensional Applications
Abstract
1. Introduction
2. Synthesis and Properties of Hydrogels
2.1. Impact of Gamma and Electron Beam Radiation
2.2. Gamma Radiation-Induced Hydrogel Synthesis
2.3. Viscoelastic Properties of Radiation-Induced Hydrogels
3. Electron Beam Irradiation Synthesis
- Electron beam (EB) radiation is an environmentally friendly process that does not require chemicals, ensuring a clean and sustainable treatment method.
- EB radiation can uniformly penetrate materials deeply, enabling the precise sterilization and modification of substances.
- This technology is rapid, cost-effective, and easily scalable for industrial production, providing efficiency in various applications.
- EB radiation leaves no harmful residues or by-products, ensuring the safety and purity of treated materials.
- The controlled processing parameters of EB radiation allow for customizable outcomes in fields such as healthcare, food preservation, and materials science.

4. UV Radiation Hydrogel Synthesis
5. Brief Application of Hydrogels
5.1. Pharmaceuticals Application
5.2. Biomedical Engineering
5.2.1. Skin Care
5.2.2. Cancer Therapy
5.2.3. Drug Delivery System
5.3. Application of Hydrogel: In Agriculture
5.4. Hydrogel as a Potting Medium
6. Conclusions and Future Direction
Author Contributions
Funding
Institutional Review Board Statement
Informed Consent Statement
Data Availability Statement
Conflicts of Interest
References
- Caliari, S.R.; Burdick, J.A. A practical guide to hydrogels for cell culture. Nat. Methods 2016, 13, 405–414. [Google Scholar] [CrossRef] [PubMed]
- Zheng, L.; Liu, S.; Cheng, X.; Qin, Z.; Lu, Z.; Zhang, K.; Zhao, J. Intensified Stiffness and Photodynamic Provocation in a Collagen-Based Composite Hydrogel Drive Chondrogenesis. Adv. Sci. 2019, 6, 1900099. [Google Scholar] [CrossRef] [PubMed]
- Slaughter, B.V.; Khurshid, S.S.; Fisher, O.Z.; Khademhosseini, A.; Peppas, N.A. Hydrogels in regenerative medicine. Adv. Mater. 2009, 21, 3307–3329. [Google Scholar] [CrossRef] [PubMed]
- Chronopoulou, L.; Di Nitto, A.; Papi, M.; Parolini, O.; Falconi, M.; Teti, G.; Muttini, A.; Lattanzi, W.; Palmieri, V.; Ciasca, G.; et al. Biosynthesis and physico-chemical characterization of high performing peptide hydrogels@graphene oxide composites. Colloids Surf. B Biointerfaces 2021, 207, 111989. [Google Scholar] [CrossRef] [PubMed]
- Amine, K.M.; Champagne, C.P.; Salmieri, S.; Britten, M.; St-Gelais, D.; Fustier, P.; Lacroix, M. Effect of palmitoylated alginate microencapsulation on viability of Bifidobacterium longum during freeze-drying. LWT-Food Sci. Technol. 2014, 56, 111–117. [Google Scholar] [CrossRef]
- Lin, C.-C.; Metters, A.T. Hydrogels in controlled release formulations: Network design and mathematical modelling. Adv. Drug Deliv. Rev. 2006, 58, 1379–1408. [Google Scholar] [CrossRef] [PubMed]
- Ahmed, E.M. Hydrogel: Preparation, characterization, and applications: A review. J. Adv. Res. 2015, 6, 105–121. [Google Scholar] [CrossRef] [PubMed]
- Gaharwar, A.K.; Peppas, N.A.; Khademhosseini, A. Nanocomposite hydrogels for biomedical applications. Biotechnol. Bioeng. 2013, 112, 441–453. [Google Scholar] [CrossRef] [PubMed]
- Zhang, M.; Zhao, X. Alginate hydrogel dressings for advanced wound management. Int. J. Biol. Macromol. 2020, 162, 1414–1428. [Google Scholar] [CrossRef] [PubMed]
- Dong, Y.; Li, S.; Li, X.; Wang, X. Smart MXene/agarose hydrogel with photothermal property for controlled drug release. Int. J. Biol. Macromol. 2021, 190, 693–699. [Google Scholar] [CrossRef]
- Chan, D.; Chien, J.-C.; Axpe, E.; Blankemeier, L.; Baker, S.W.; Swaminathan, S.; Piunova, V.A.; Zubarev, D.Y.; Maikawa, C.L.; Grosskopf, A.K.; et al. Combinatorial Polyacrylamide Hydrogels for Preventing Biofouling on Implantable Biosensors. Adv. Mater. 2022, 34, 2109764. [Google Scholar] [CrossRef] [PubMed]
- Daza Agudelo, J.I.; Ramirez, M.R.; Henquin, E.R.; Rintoul, I. Modelling of swelling of PVA hydrogels considering non-ideal mixing behaviour of PVA and water. J. Mater. Chem. B. 2019, 7, 4049–4054. [Google Scholar] [CrossRef]
- Chen, G.; Tang, W.; Wang, X.; Zhao, X.; Chen, C.; Zhu, Z. Applications of hydrogels with special physical properties in biomedicine. Polymers 2019, 11, 1420. [Google Scholar] [CrossRef] [PubMed]
- Thangprasert, A.; Tansakul, C.; Thuaksubun, N.; Meesane, J. Mimicked hybrid hydrogel based on gelatin/PVA for tissue engineering in subchondral bone interface for osteoarthritis surgery. Mater. Des. 2019, 183, 108113. [Google Scholar] [CrossRef]
- Gong, Z.; Zhang, G.; Zeng, X.; Li, J.; Li, G.; Huang, W.; Sun, R.; Wong, C. High-Strength, Tough, Fatigue Resistant, and Self-Healing Hydrogel Based on Dual Physically Cross-Linked Network. ACS Appl. Mater. Interfaces 2016, 8, 24030–24037. [Google Scholar] [CrossRef] [PubMed]
- Ortega, A.; Valencia, S.; Rivera, E.; Segura, T.; Burillo, G. Reinforcement of Acrylamide Hydrogels with Cellulose Nanocrystals Using Gamma Radiation for Antibiotic Drug Delivery. Gels 2023, 9, 602. [Google Scholar] [CrossRef] [PubMed]
- Yang, P.; Ju, Y.; Hu, Y.; Xie, X.; Fang, B.; Lei, L. Emerging 3D bioprinting applications in plastic surgery. Biomater. Res. 2023, 27, 1. [Google Scholar] [CrossRef] [PubMed]
- Yang, L.; Wang, X.; Yu, Y.; Shang, L.; Xu, W.; Zhau, Y. Bio-inspired dual-adhesive particles from microfluidic electrospray for bone regeneration. Nano. Res. 2023, 16, 5292–5299. [Google Scholar] [CrossRef]
- Chen, Z.; Zhao, D.; Liu, B.; Nian, G.; Li, X.; Yin, J.; Qu, S.; Yang, W. 3D Printing of Multifunctional Hydrogels. Adv. Funct. Mater. 2019, 29, 1900971. [Google Scholar] [CrossRef]
- Peppas, N.A.; Merrill, E.W. Determination of Interaction Parameter X1 for Poly(Vinyl Alcohol) and Water in Gels Crosslinked From Solutions. J. Polym. Sci. Polym. Chem. Ed. 1976, 14, 459–464. [Google Scholar] [CrossRef]
- Ma, S.; Wang, S.; Li, Q.; Leng, Y.; Wang, L.; Hu, G.H. A Novel Method for Preparing Poly(vinyl alcohol) Hydrogels: Preparation, Characterization, and Application. Ind. Eng. Chem. Res. 2017, 56, 7971–7976. [Google Scholar] [CrossRef]
- Bustamante, P.; Anessi, C.; Santoro, N.; Ciavaro, N.; Horak, C. Synthesis and Characterization of Hydrogels Cross-Linked with Gamma Radiation for use as Wound Dressings. Acta Sci. Med. Sci. 2019, 3, 130–134. [Google Scholar]
- Caló, E.; Khutoryanskiy, V.V. Biomedical applications of hydrogels: A review of patents and commercial products. Eur. Polym. J. 2015, 65, 252–267. [Google Scholar] [CrossRef]
- Lieleg, O.; Ribbeck, K. Biological hydrogels as selective diffusion barriers. Trends Cell Biol. 2011, 21, 543–551. [Google Scholar] [CrossRef]
- Hoffman, A.S. Hydrogels for biomedical applications. Adv. Drug Deliv. Rev. 2012, 64, 18–23. [Google Scholar] [CrossRef]
- Sabatino, M.A.; Bulone, D.; Veres, M.; Spinella, A.; Spadaro, G.; Dispenza, C. Structure of e-beam sculptured poly(N-vinylpyrrolidone) networks across different length-scales, from macro to nano. Polymer 2013, 54, 54–64. [Google Scholar] [CrossRef]
- Abdel Ghaffar, A.M.; Radwan, R.R.; Ali, H.E. Radiation Synthesis of Poly(Starch/Acrylic acid) pH Sensitive Hydrogel for Rutin Controlled Release. Int. J. Biol. Macromol. 2016, 92, 957–964. [Google Scholar] [CrossRef] [PubMed]
- Raza, M.A.; Jeong, J.O.; Park, S.H. State-of-the-Art Irradiation Technology for Polymeric Hydrogel Fabrication and Application in Drug Release System. Front. Mater. 2021, 8, 769436. [Google Scholar] [CrossRef]
- Giammona, G.; Pitarresi, G.; Cavallaro, G.; Spadaro, G. New biodegradable hydrogels based on an acryloylated polyaspartamide cross-linked by gamma irradiation. J. Biomater. Sci. Polym. Ed. 1999, 9, 969–987. [Google Scholar] [CrossRef] [PubMed]
- Wisotzki, E.I.; Hennes, M.; Schuldt, C.; Engert, F.; Knolle, W.; Decker, U. Tailoring the material properties of gelatin hydrogels by high energy electron irradiation. J. Mater. Chem. B. 2014, 2, 4297–4309. [Google Scholar] [CrossRef] [PubMed]
- Shirai, M. Photocrosslinkable polymers with degradable properties. Polym. J. 2014, 46, 859–865. [Google Scholar] [CrossRef]
- Fan, B.; Zhang, K.; Liu, Q.; Eelkema, R. Self-Healing Injectable Polymer Hydrogel via Dynamic Thiol-Alkynone Double Addition Cross-Links. ACS Macro Lett. 2020, 9, 776–780. [Google Scholar] [CrossRef]
- Kalayci, K.; Frisch, H.; Barner-Kowollik, C.; Truong, V.X. Wavelength-Dependent Stiffening of Hydrogel Matrices via Redshifted [2+2] Photocycloadditions. Adv. Funct. Mater. 2020, 30, 1908171. [Google Scholar] [CrossRef]
- Szafulera, K.; Wach, R.A.; Olejnik, A.K.; Rosiak, J.M.; Ulański, P. Radiation synthesis of biocompatible hydrogels of dextran methacrylate. Radiat. Phys. Chem. 2018, 142, 115–120. [Google Scholar] [CrossRef]
- Fei, B.; Wach, R.A.; Mitomo, H.; Yoshii, F.; Kume, T. Hydrogel of biodegradable cellulose derivatives. I. Radiation-induced crosslinking of CMC. J. Appl. Polym. Sci. 2000, 78, 278–283. [Google Scholar] [CrossRef]
- Cataldo, F.; Ursini, O.; Lilla, E.; Angelini, G. Radiation-induced crosslinking of collagen gelatin into a stable hydrogel. J. Radioanal. Nucl. Chem. 2008, 275, 125–131. [Google Scholar] [CrossRef]
- Ashfaq, A.; Clochard, M.C.; Coqueret, X.; Dispenza, C.; Driscoll, M.S.; Ulański, P. Polymerization reactions and modifications of polymers by ionizing radiation. Polymers 2020, 12, 2877. [Google Scholar] [CrossRef] [PubMed]
- Park, J.; Kim, M.; Choi, S.; Sun, J.Y. Self-healable soft shield for γ-ray radiation based on polyacrylamide hydrogel composites. Sci. Rep. 2020, 10, 21689. [Google Scholar] [CrossRef] [PubMed]
- Sharma, B.K.; Krishnanand, K.; Mahanwar, P.; Sarma, K.; Chowdhury, S.R. Gamma radiation aging of EVA/EPDM blends: Effect of vinyl acetate (VA) content and radiation dose on the alteration in mechanical, thermal, and morphological behavior. J. Appl. Polym. Sci. 2018, 135, 46216. [Google Scholar] [CrossRef]
- Rouif, S. Radiation cross-linked polymers: Recent developments and new applications. Nucl. Instrum. Methods Phys. Res. Sect. B Beam Interact. Mater. At. 2005, 236, 68–72. [Google Scholar] [CrossRef]
- Bhattacharya, A. Radiation and industrial polymers. Prog. Polym. Sci. 2000, 25, 371–401. [Google Scholar] [CrossRef]
- Cota, S.S.; Vasconcelos, V.; Senne, M.; Carvalho, L.L.; Rezende, D.B.; Correa, R.F. Changes in mechanical properties due to gamma irradiation of high-density polyethylene (HDPE). Braz. J. Chem. Eng. 2007, 24, 259–265. [Google Scholar] [CrossRef]
- Abd Alla, S.G.; Sen, M.; El-Naggar, A.W.M. Swelling and mechanical properties of superabsorbent hydrogels based on Tara gum/acrylic acid synthesized by gamma radiation. Carbohydr. Polym. 2012, 89, 478–485. [Google Scholar] [CrossRef] [PubMed]
- Magda, J.; Cho, S.H.; Streitmatter, S.; Jevremovic, T. Effects of gamma rays and neutron irradiation on the glucose response of boronic acid-containing “smart” hydrogels. Polym. Degrad. Stab. 2014, 99, 219–222. [Google Scholar] [CrossRef]
- Gottlieb, R.; Schmidt, T.; Arndt, K.F. Synthesis of temperature-sensitive hydrogel blends by high-energy irradiation. Nucl. Instrum. Methods Phys. Res. Sect. B Beam Interact. Mater. At. 2005, 236, 371–376. [Google Scholar] [CrossRef]
- Jha, P.K.; Jha, R.; Gupta, B.L.; Guha, S.K. Effect of γ-dose rate and total dose interrelation on the polymeric hydrogel: A novel injectable male contraceptive. Radiat. Phys. Chem. 2010, 79, 663–671. [Google Scholar] [CrossRef]
- Ashley, G.W.; Henise, J.; Reid, R.; Santi, D.V. Hydrogel drug delivery system with predictable and tunable drug release and degradation rates. Proc. Natl. Acad. Sci. USA 2013, 110, 2318–2323. [Google Scholar] [CrossRef] [PubMed]
- Gadziński, P.; Froelich, A.; Jadach, B.; Wojtyłko, M.; Tatarek, A.; Białek, A.; Krysztofiak, J.; Gackowski, M.; Otto, F.; Osmałek, T. Ionotropic Gelation and Chemical Crosslinking as Methods for Fabrication of Modified-Release Gellan Gum-Based Drug Delivery Systems. J. Pharm. 2023, 15, 108. [Google Scholar] [CrossRef] [PubMed]
- Ajji, Z.; Othman, I.; Rosiak, J.M. Production of hydrogel wound dressings using gamma radiation. Nucl. Instrum. Methods Phys. Res. Sect. B Beam Interact. Mater. At. 2005, 229, 375–380. [Google Scholar] [CrossRef]
- Juby, K.A.; Dwivedi, C.; Kumar, M.; Kota, S.; Misra, H.; Bajaj, P.N. Silver nanoparticle-loaded PVA/gum acacia hydrogel: Synthesis, characterization and antibacterial study. Carbohydr. Polym. 2012, 89, 906–913. [Google Scholar] [CrossRef] [PubMed]
- Can, H.K.; Denizli, B.K.; Kavlak, S.; Guner, A. Preparation and swelling studies of biocompatible hydrogel systems by using gamma radiation-induced polymerization. Radiat. Phys. Chem. 2005, 72, 483–488. [Google Scholar] [CrossRef]
- Zhao, L.; Gwon, H.J.; Lim, Y.M.; Nho, Y.C.; Kim, S.Y. Gamma ray-induced synthesis of hyaluronic acid/chondroitin sulfate-based hydrogels for biomedical applications. Radiat. Phys. Chem. 2015, 106, 404–412. [Google Scholar] [CrossRef]
- El-Din, H.M.N.; Abou Taleb, M.F.; El-Naggar, A.W.M. Metal sorption and swelling characters of acrylic acid and sodium alginate-based hydrogels synthesized by gamma irradiation. Nucl. Instrum. Methods Phys. Res. Sect. B Beam Interact. Mater. At. 2008, 266, 2607–2613. [Google Scholar] [CrossRef]
- Wang, Z.; Ye, Q.; Yu, S.; Akhavan, B. Polyethylene Glycol (PEG)-Based Hydrogels for Drug Delivery in Cancer Therapy: A Comprehensive Review. Adv. Healthc. Mater. 2023, 12, 2300105. [Google Scholar] [CrossRef] [PubMed]
- Fu, P.-S.; Wang, J.-C.; Lai, P.-L.; Liu, S.-M.; Chen, Y.-S.; Chen, W.-C.; Hung, C.-C. Effects of gamma radiation on the sterility assurance, antibacterial ability, and biocompatibility of impregnated hydrogel macrosphere protein and drug release. Polymers 2021, 13, 938. [Google Scholar] [CrossRef] [PubMed]
- Mignon, A.; Zimmer, J.; Gutierrez Cisneros, C.; Kühnert, M.; Derveaux, E.; Daikos, O.; Scherzer, T.; Adriaensens, P.; Schulze, A. Electron-Beam-Initiated Crosslinking of Methacrylated Alginate and Diacrylated Poly(ethylene glycol) Hydrogels. Polymers 2023, 15, 4685. [Google Scholar] [CrossRef] [PubMed]
- Pramanik, N.K.; Katamgari, I.; Dey, A.; Bhardwaj, Y.K.; Alam, T.; Chattopadhyay, S.K.; Saha, N.C. Electron beam irradiation on monolayer plastic packaging films: Studies on physico-mechanical and thermal properties. Packag. Technol. Sci. 2021, 34, 475–483. [Google Scholar] [CrossRef]
- Ansari, M.J.; Rajendran, R.R.; Mohanto, S.; Agarwal, U.; Panda, K.; Dhotre, K.; Deepak, A.; Zafar, A.; Yasir, M.; Pramanik, S.; et al. Poly(N-isopropylacrylamide)-Based Hydrogels for Biomedical Applications: A Review of the State-of-the-Art. Gels 2022, 8, 454. [Google Scholar] [CrossRef] [PubMed]
- Tomatsu, I.; Peng, K.; Kros, A. Photoresponsive hydrogels for biomedical applications. Adv. Drug Deliv. Rev. 2011, 63, 1257–1266. [Google Scholar] [CrossRef] [PubMed]
- Abd El-Mohdy, H.L.; Hegazy, E.A.; El-Nesr, E.M.; El-Wahab, M.A. Synthesis, characterization and properties of radiation-induced Starch/(EG-co-MAA) hydrogels. Arab. J. Chem. 2016, 9, 1627–1635. [Google Scholar] [CrossRef]
- Haleem, A.; Chen, S.; Pan, J.; Weidong, H. Gamma radiation induced synthesis of double network hydrophilic cryogels at low pH loaded with AuNPs for fast and efficient degradation of Congo red. J. Hazard. Mater. Adv. 2023, 10, 100299. [Google Scholar] [CrossRef]
- Din, M.I.; Khalid, R.; Hussain, Z.; Hussain, T.; Mujahid, A.; Najeeb, J. Nanocatalytic Assemblies for Catalytic Reduction of Nitrophenols: A Critical Review. Crit. Rev. Anal. Chem. 2020, 50, 322–338. [Google Scholar] [CrossRef] [PubMed]
- Sabadasch, V.; Dirksen, M.; Fandrich, P.; Cremer, J.; Biere, N.; Anselmetti, D. Pd Nanoparticle-Loaded Smart Microgel-Based Membranes as Reusable Catalysts. ACS Appl. Mater. Interfaces 2022, 14, 49181–49188. [Google Scholar] [CrossRef] [PubMed]
- Elhady, M.A.; Mousaa, I.M.; Attia, R.M. Preparation of a novel superabsorbent hydrogel based on polyacrylic acid/shellac using gamma irradiation for adsorption removal of malachite green dye. Polym. Polym. Compos. 2022, 30, 1–15. [Google Scholar] [CrossRef]
- Sayed, A.; Hany, F.; Abdel-Raouf, M.E.S.; Mahmoud, G.A. Gamma irradiation synthesis of pectin-based biohydrogels for removal of lead cations from simulated solutions. J. Polym. Res. 2022, 29, 372. [Google Scholar] [CrossRef]
- Bhuyan, M.M.; Dafader, N.C.; Hara, K.; Okabe, H.; Hidaka, Y.; Rahman, M.M. Synthesis of Potato Starch-Acrylic-Acid Hydrogels by Gamma Radiation and Their Application in Dye Adsorption. Int. J. Polym. Sci. 2016, 2016, 9867859. [Google Scholar] [CrossRef]
- Bhuyan, M.M.; Jeong, J.H. Synthesis and Characterization of Gamma Radiation Induced Diallyldimethylammonium Chloride-Acrylic Acid-(3-Acrylamidopropyl) Trimethylammonium Chloride Superabsorbent Hydrogel. Gels 2023, 9, 159. [Google Scholar] [CrossRef] [PubMed]
- Bhuyan, M.M.; Jeong, J.H. Gamma Radiation-Induced Advanced 2,3-Dimethylacrylic Acid-(2-Acrylamido-2-methyl-1-propanesulfonic Acid) Superabsorbent Hydrogel: Synthesis and Characterization. Gels 2023, 9, 426. [Google Scholar] [CrossRef] [PubMed]
- Tinoco, D.; Ortega, A.; Burillo, G.; Islas, L.; García-Uriostegui, L. Different hydrogel architectures synthesized by gamma radiation based on chitosan and N,N-dimethylacrylamide. MRS Commun. 2018, 8, 617–623. [Google Scholar] [CrossRef]
- Francis, S.; Mitra, D.; Dhanawade, B.R.; Varshney, L.; Sabharwal, S. Gamma radiation synthesis of rapid swelling superporous polyacrylamide hydrogels. Radiat. Phys. Chem. 2009, 78, 951–953. [Google Scholar]
- Jeong, J.O.; Park, J.S.; Kim, Y.A.; Yang, S.J.; Jeong, S.I.; Lee, J.Y. Gamma Ray-Induced Polymerization and Cross-Linking for Optimization of PPy/PVP Hydrogel as Biomaterial. Polymers 2020, 12, 111. [Google Scholar] [CrossRef] [PubMed]
- Ishak, W.H.W.; Ahmad, I.; Ramli, S.; Amin, M.C.I.M. Gamma irradiation-assisted synthesis of cellulose nanocrystal-reinforced gelatin hydrogels. Nanomaterials 2018, 8, 749. [Google Scholar] [CrossRef] [PubMed]
- Kumaraswamy, S.; Babaladimath, G.; Badalamoole, V.; H Mallaiah, S. Gamma irradiation synthesis and in vitro drug release studies of ZnO/PVA hydrogel nanocomposites. Adv. Mater. Lett. 2017, 8, 546–552. [Google Scholar] [CrossRef]
- Abdel Maksoud, M.I.A.; Abdelhaleem, S.; Tawfik, E.K.; Awed, A.S. Gamma radiation-induced synthesis of novel PVA/Ag/CaTiO3 nanocomposite film for flexible optoelectronics. Sci. Rep. 2023, 13, 12385. [Google Scholar] [CrossRef] [PubMed]
- Zhang, W.; Chen, R.; Xu, X.; Zhu, L.; Liu, Y.; Yu, X.; Tang, G. Hydrogel Scaffolds with a Long-Term Drug Release for Facilitating Cartilage Repair. Front. Pharmacol. 2022, 13, 922032. [Google Scholar] [CrossRef] [PubMed]
- Kim, S.A.; Lee, Y.; Park, K.; Park, J.; An, S.; Oh, J.; Kang, M.; Lee, Y.; Jo, Y.; Cho, S.-W.; et al. 3D printing of mechanically tough and self-healing hydrogels with carbon nanotube fillers. Int. J. Bioprint. 2023, 9, 765. [Google Scholar] [CrossRef] [PubMed]
- Jiang, F.; Wang, X.; He, C.; Saricilar, S.; Wang, H. Mechanical properties of tough hydrogels synthesized with a facile simultaneous radiation polymerization and cross-linking method. Radiat. Phys. Chem. 2015, 106, 7–15. [Google Scholar] [CrossRef]
- Herrmann, A.; Haag, R.; Schedler, U. Hydrogels and Their Role in Biosensing Applications. Adv. Healthc. Mater. 2021, 10, 2100062. [Google Scholar] [CrossRef] [PubMed]
- Atia, G.A.N.; Shalaby, H.K.; Ali, N.G.; Morsy, S.M.; Ghobashy, M.M.; Attia, H.A.N.; Barai, P.; Nady, N.; Kodous, A.S.; Barai, H.R. New Challenges and Prospective Applications of Three-Dimensional Bioactive Polymeric Hydrogels in Oral and Craniofacial Tissue Engineering: A Narrative Review. Pharmaceuticals 2023, 16, 702. [Google Scholar] [CrossRef] [PubMed]
- Yang, J.; Rao, L.; Wang, Y.; Zhao, Y.; Liu, D.; Wang, Z.; Fu, L.; Wang, Y.; Yang, X.; Li, Y.; et al. Recent Advances in Smart Hydrogels Prepared by Ionizing Radiation Technology for Biomedical Applications. Polymers 2022, 14, 4377. [Google Scholar] [CrossRef] [PubMed]
- Lung, H.M.; Cheng, Y.C.; Chang, Y.H.; Huang, H.W.; Yang, B.B.; Wang, C.Y. Microbial decontamination of food by electron beam irradiation. Trends Food Sci. Technol. 2015, 44, 66–78. [Google Scholar] [CrossRef]
- Liu, Y.; Wang, J.; Chen, H.; Cheng, D. Environmentally friendly hydrogel: A review of classification, preparation, and application in agriculture. Sci. Total Environ. 2022, 846, 157303. [Google Scholar] [CrossRef] [PubMed]
- Gupta, T.; Strelcov, E.; Holland, G.; Schumacher, J.; Yang, Y.; Esch, M.; Aksyuk, V.; Zeller, P.; Amati, M.; Gregoratti, L.; et al. Focused electron and X-ray beam crosslinking in liquids for nanoscale hydrogels 3D printing and encapsulation. ACS Nano 2020, 14, 12982–12992. [Google Scholar] [CrossRef] [PubMed]
- Ajji, Z.; Mirjalili, G.; Alkhatab, A.; Dada, H. Use of electron beam for the production of hydrogel dressings. Radiat. Phys. Chem. 2008, 77, 200–202. [Google Scholar] [CrossRef]
- Krömmelbein, C.; Xie, X.; Seifert, J.; Konieczny, R.; Friebe, S.; Käs, J. Electron beam treated injectable agarose/alginate beads prepared by electrospraying. Carbohydr. Polym. 2022, 298, 120024. [Google Scholar] [CrossRef] [PubMed]
- Krömmelbein, C.; Mütze, M.; Konieczny, R.; Schönherr, N.; Griebel, J.; Gerdes, W. Impact of high-energy electron irradiation on mechanical, structural and chemical properties of agarose hydrogels. Carbohydr. Polym. 2021, 263, 117970. [Google Scholar] [CrossRef] [PubMed]
- Girard-Perier, N.; Dorey, S.; Marque, S.R.A.; Dupuy, N. Mapping the scientific research on the ionizing radiation impacts on polymers (1975–2019). E-Polymers 2021, 21, 770–778. [Google Scholar] [CrossRef]
- Hooshangi, Z.; Feghhi, S.A.H.; Sheikh, N. The effect of electron-beam irradiation and halogen-free flame retardants on properties of poly butylene terephthalate. Radiat. Phys. Chem. 2015, 108, 54–59. [Google Scholar] [CrossRef]
- Bhowmick, A.K.; Shanmugharaj, A.M.; Vijayabaskar, V. Electron beam processing of rubbers and their composites. Int. Polym. Process. 2022, 37, 471–504. [Google Scholar]
- Abou Elmaaty, T.; Okubayashi, S.; Elsisi, H.; Abouelenin, S. Electron beam irradiation treatment of textiles materials: A review. J. Polym. Res. 2022, 29, 117. [Google Scholar] [CrossRef]
- Zhang, S.; Ding, F.; Wang, Y.; Ren, X.; Huang, T.S. Antibacterial and Hydrophilic Modification of PET Fabrics by Electron Beam Irradiation Process. Fibers Polym. 2020, 21, 1023–1031. [Google Scholar] [CrossRef]
- Aljeboree, A.M.; Alkaim, A.F. Studying removal of anionic dye by prepared highly adsorbent surface hydrogel nanocomposite as an applicable for aqueous solution. Sci. Rep. 2024, 24, 9202. [Google Scholar] [CrossRef] [PubMed]
- Dai, D.; Shi, M. Effects of electron beam irradiation on structure and properties of ultra-high molecular weight polyethylene fiber. J. Ind. Text. 2018, 47, 1357–1377. [Google Scholar] [CrossRef]
- Okumura, Y.; Takata, Y. Consideration on Electron Beam Cross-linked Polyethylene. Ind. Mater. 2023, 96, 123–127. [Google Scholar]
- Glass, S.; Kühnert, M.; Abel, B.; Schulze, A. Controlled electron-beam synthesis of transparent hydrogels for drug delivery applications. Polymers 2019, 11, 501. [Google Scholar] [CrossRef] [PubMed]
- Onn, M.; Zaiton, S.N.A.; Othman, Z.S.; Rahman, F.A.; Dahlan, K.Z.M. The effect of electron beam radiation on mechanical stability of polybutylene succinate polymer. Chem. Eng. Trans. 2018, 63, 799–804. [Google Scholar]
- Craciun, G.; Manaila, E.; Stelescu, M.D. Electron Beam Synthesis and Characterization of Acrylamide/Acrylic Acid Hydrogels Using Trimethylolpropane Trimethacrylate as Cross-Linker. J. Chem. 2016, 2016, 1470965. [Google Scholar] [CrossRef]
- Vieira, F.F.; Del Mastro, N.L. Comparison of γ-radiation and electron beam irradiation effects on gelatin. Radiat. Phys. Chem. 2002, 63, 331–332. [Google Scholar] [CrossRef]
- Kolmakov, A.; Gupta, T.; Strelcov, E.; Holland, G.; Schumacher, J.; Yang, Y. Electron and X-ray focused beam-induced cross-linking in liquids: Toward rapid continuous 3d nanoprinting and interfacing using soft materials. ACS Nano 2020, 14, 12982–12992. [Google Scholar]
- Je, M.; Son, H.B.; Han, Y.J.; Jang, H.; Kim, S.; Kim, D. Formulating Electron Beam-Induced Covalent Linkages for Stable and High-Energy-Density Silicon Microparticle Anode. Adv. Sci. 2024, 11, 2305298. [Google Scholar] [CrossRef] [PubMed]
- Liu, Z.; Ma, R.; Du, W.; Yang, G.; Chen, T. Radiation-initiated high strength chitosan/lithium sulfonate double network hydrogel/aerogel with porosity and stability for efficient CO2 capture. RSC Adv. 2021, 11, 20486–20497. [Google Scholar] [CrossRef]
- Masutani, E.M.; Kinoshita, C.K.; Tanaka, T.T.; Ellison, A.K.D.; Yoza, B.A. Increasing thermal stability of gelatin by UV-induced cross-linking with glucose. Int. J. Biomater. 2014, 2014, 979636. [Google Scholar] [CrossRef] [PubMed]
- Cao, H.; Duan, L.; Zhang, Y.; Cao, J.; Zhang, K. Current hydrogel advances in physicochemical and biological response-driven biomedical application diversity. Signal Transduct. Target. Ther. 2021, 6, 426. [Google Scholar] [CrossRef] [PubMed]
- Ullah, F.; Othman, M.B.H.; Javed, F.; Ahmad, Z.; Akil, H.M. Classification, processing, and application of hydrogels: A review. Mater. Sci. Eng. C 2015, 57, 414–433. [Google Scholar] [CrossRef] [PubMed]
- Hwang, I.T.; Kim, M.B.; Sohn, J.Y.; Shin, J.; Seo, H.S.; Ji, H.J.; Jeong, J.-H.; Hwang, C.; Song, G.; Song, H.-K.; et al. Green and efficient radiation-based preparation of crosslinked poly(vinyl pyrrolidone)-iodine (PVP-I)-introduced polypropylene (PP) sheets for antibacterial wound dressing application. Eur. Polym. J. 2024, 208, 112848. [Google Scholar] [CrossRef]
- Rosiak, J.M.; Yoshii, F. Hydrogels and their medical applications. Nucl. Instrum. Methods Phys. Res. B 1999, 151, 56–64. [Google Scholar] [CrossRef]
- Zhong, R.; Talebian, S.; Mendes, B.B.; Wallace, G.; Langer, R.; Conde, J.; Shi, J. Hydrogels for RNA delivery. Nat. Mater. 2023, 22, 818–831. [Google Scholar] [CrossRef] [PubMed]
- Michida, N.; Hayashi, M.; Hori, T. Comparison of event related potentials with and without hypnagogic imagery. Psychiatry Clin. Neurosci. 1998, 52, 145–147. [Google Scholar] [CrossRef] [PubMed]
- Gupta, P.; Vermani, K.; Garg, S. Hydrogels: From controlled release to pH-responsive drug delivery. Drug Discov. Today 2002, 7, 569–579. [Google Scholar] [CrossRef] [PubMed]
- Deuflhard, M.; Eberbeck, D.; Hietschold, P.; Wilharm, N.; Mühlberger, M.; Friedrich, R.P. Magnetically responsive composites: Electron beam assisted magnetic nanoparticle arrest in gelatin hydrogels for bioactuation. Phys. Chem. Chem. Phys. 2019, 21, 14654–14662. [Google Scholar] [CrossRef] [PubMed]
- Şener Raman, T.; Kuehnert, M.; Daikos, O.; Scherzer, T.; Krömmelbein, C.; Mayr, S.G. A study on the material properties of novel PEGDA/gelatin hybrid hydrogels polymerized by electron beam irradiation. Front. Chem. 2023, 10, 1094981. [Google Scholar] [CrossRef] [PubMed]
- Manaila, E.; Craciun, G.; Ighigeanu, D.; Cimpeanu, C.; Barna, C.; Fugaru, V. Hydrogels synthesized by electron beam irradiation for heavy metal adsorption. Materials 2017, 10, 540. [Google Scholar] [CrossRef] [PubMed]
- Nguyen, M.N.; Loulergue, P.; Karpel, N.; Teychene, B. Electron beam irradiation of polyvinylidene fluoride/polyvinylpyrrolidone ultrafiltration membrane in presence of zwitterions molecules evaluation of filtration performances. Radiat. Phys. Chem. 2019, 159, 101–110. [Google Scholar] [CrossRef]
- Liu, M.; Yu, W.; Fang, Y.; Zhou, H.; Liang, Y.; Huang, C.; Liu, H.; Zhao, G. Pyruvate and lactate based hydrogel film inhibits UV radiation-induced skin inflammation and oxidative stress. Int. J. Pharm. 2023, 634, 122697. [Google Scholar] [CrossRef] [PubMed]
- Hao, J.; Sun, M.; Li, D.; Zhang, T.; Li, J.; Zhou, D. An IFI6-based hydrogel promotes the healing of radiation-induced skin injury through regulation of the HSF1 activity. J. Nanobiotechnol. 2022, 20, 288. [Google Scholar] [CrossRef] [PubMed]
- Hao, Y.; Li, H.; Guo, J.; Wang, D.; Zhang, J.; Liu, J. Bio-Inspired Antioxidant Heparin-Mimetic Peptide Hydrogel for Radiation-Induced Skin Injury Repair. Adv. Healthc. Mater. 2023, 12, 2203387. [Google Scholar] [CrossRef] [PubMed]
- Su, Y.; Cui, H.; Yang, C.; Li, L.; Xu, F.; Gao, J. Hydrogels for the treatment of radiation-induced skin and mucosa damages: An up-to-date overview. Front. Mater. 2022, 9, 1018815. [Google Scholar] [CrossRef]
- Tian, Y.; Wang, Z.; Cao, S.; Liu, D.; Zhang, Y.; Chen, C. Connective tissue inspired elastomer-based hydrogel for artificial skin via radiation-indued penetrating polymerization. Nat. Commun. 2024, 15, 636. [Google Scholar] [CrossRef] [PubMed]
- Zaharescu, T.; Varca, G.H.C. Radiation modified polymers for medical applications. Radiat. Phys. Chem. 2022, 194, 110043. [Google Scholar] [CrossRef]
- Ningyue, X.; Jun, W.; Lei, L.; Changyang, G. Injectable hydrogel-based drug delivery systems for enhancing the efficacy of radiation therapy: A review of recent advances. Chin. Chem. Lett. 2024, 34, 109225. [Google Scholar]
- .Minhas, M.U.; Ahmad, M.; Anwar, J.; Khan, S. Synthesis and Characterization of Biodegradable Hydrogels for Oral Delivery of 5-Fluorouracil Targeted to Colon: Screening with Preliminary In Vivo Studies. Adv. Polym. Technol. 2018, 37, 21659. [Google Scholar] [CrossRef]
- Jeong, S.I.; Park, S.-C.; Park, S.-J.; Kim, E.-J.; Heo, H.; Park, J.-S.; Gwon, H.-J.; Lim, Y.-M.; Jang, M.-K. One-step synthesis of gene carrier via gamma irradiation and its application in tumor gene therapy. Int. J. Nanomed. 2018, 13, 525–536. [Google Scholar] [CrossRef] [PubMed]
- Meng, D.; Yang, S.; Yang, Y.; Zhang, L.; Cui, L. Synergistic chemotherapy and phototherapy based on red blood cell biomimetic nanomaterials. J. Control. Release 2022, 352, 146–162. [Google Scholar] [CrossRef] [PubMed]
- Lee, J.H.; Tachibana, T.; Yamana, K.; Kawasaki, R.; Yabuki, A. Simple Formation of Cancer Drug-Containing Self-Assembled Hydrogels with Temperature and pH-Responsive Release. Langmuir 2021, 37, 11269–11275. [Google Scholar] [CrossRef] [PubMed]
- Wang, N.; Gao, Q.; Tang, J.; Jiang, Y.Q.; Yang, L.S.; Shi, X.X. Anti-tumor effect of local injectable hydrogel-loaded endostatin alone and in combination with radiotherapy for lung cancer. Drug Deliv. 2021, 28, 183–194. [Google Scholar] [CrossRef] [PubMed]
- Zhang, J.; Yang, L.; Huang, F.; Zhao, C.; Liu, J.; Zhang, Y. Multifunctional Hybrid Hydrogel Enhanced Antitumor Therapy through Multiple Destroying DNA Functions by a Triple-Combination Synergistic Therapy. Adv. Healthc. Mater. 2021, 10, 2101190. [Google Scholar] [CrossRef] [PubMed]
- Li, X.; Xu, X.; Xu, M.; Geng, Z.; Ji, P.; Liu, Y. Hydrogel systems for targeted cancer therapy. Front. Bioeng. Biotechnol. 2023, 11, 1140436. [Google Scholar] [CrossRef] [PubMed]
- Shim, J.W.; Nho, Y.C. Preparation of Poly(acrylic acid)-Chitosan Hydrogels by Gamma Irradiation and In Vitro Drug Release. J. Appl. Polym. Sci. 2003, 90, 3660–3667. [Google Scholar] [CrossRef]
- Singh, B.; Bala, R. Development of hydrogels by radiation induced polymerization for use in slow drug delivery. Radiat. Phys. Chem. 2014, 103, 178–187. [Google Scholar] [CrossRef]
- Carenza, M.; Lora, S.; Caliceti, P.; Schiavon, O.; Veronese, F.M. Hydrogels obtained by radiation-induced polymerization as delivery systems for peptide and protein drugs. Radiat. Phys. Chem. 1993, 42, 897–901. [Google Scholar] [CrossRef]
- Zheng, K.; Zhu, X.; Guo, S.; Zhang, X. Gamma-ray-responsive drug delivery systems for radiation protection. Chem. Eng. J. 2023, 463, 142522. [Google Scholar] [CrossRef]
- Gong, C.; Qi, T.; Wei, X.; Qu, Y.; Wu, Q.; Luo, F. Thermosensitive Polymeric Hydrogels As Drug Delivery Systems. Curr. Med. Chem. 2013, 20, 79–94. [Google Scholar] [CrossRef] [PubMed]
- Steffensen, S.L.; Vestergaard, M.H.; Møller, E.H.; Groenning, M.; Alm, M.; Franzyk, H. Soft hydrogels interpenetrating silicone-A polymer network for drug-releasing medical devices. J. Biomed. Mater. Res.-Part B Appl. Biomater. 2016, 104, 402–410. [Google Scholar] [CrossRef] [PubMed]
- Liu, C.; Zhang, Z.; Liu, X.; Ni, X.; Li, J. Gelatin-based hydrogels with β-cyclodextrin as a dual functional component for enhanced drug loading and controlled release. RSC Adv. 2013, 3, 25041–25049. [Google Scholar] [CrossRef]
- Ghobashy, M.M.; Amin, M.A.; Ismail, M.A.; Nowwar, A.I.; El-diehy, M.A.; Gayed, H.M. Radiation cross-linked ultra-absorbent hydrogel to rationalize irrigation water and fertilizer for maize planting in drought conditions. Int. J. Biol. Macromol. 2023, 252, 126467. [Google Scholar] [CrossRef] [PubMed]
- Radoiu, M.; Martin, D.; Oproiu, C.; Toma, M.; Popescu, A.S.; Bestea, V. Ionizing radiation in the field of hydrogels used for agriculture and medicine. Czech. J. Phys. 1999, 49, 507–512. [Google Scholar] [CrossRef]
- Raafat, A.I.; Eid, M.; El-Arnaouty, M.B. Radiation synthesis of superabsorbent CMC based hydrogels for agriculture applications. Nucl. Instrum. Methods Phys. Res. Sect. B Beam Interact. Mater. At. 2012, 283, 71–76. [Google Scholar] [CrossRef]
- Elbarbary, A.M.; El-Rehim, H.A.A.; El-Sawy, N.M.; Hegazy, E.S.A.; Soliman, E.S.A. Radiation induced crosslinking of polyacrylamide incorporated low molecular weights natural polymers for possible use in the agricultural applications. Carbohydr. Polym. 2017, 176, 19–28. [Google Scholar] [CrossRef] [PubMed]
- Barakat, L.; Badawy, R.; Emam, M. Functional applications of hydrogels in agriculture and environmental remediation. Environ. Sci. Pollut. Res. 2021, 28, 14608–14622. [Google Scholar]
- Rajanna, G.A.; Manna, S.; Singh, A.; Babu, S.; Singh, V.K.; Dass, A. Biopolymeric superabsorbent hydrogels enhance crop and water productivity of soybean–wheat system in Indo-Gangetic plains of India. Sci. Rep. 2022, 12, 11955. [Google Scholar] [CrossRef] [PubMed]
- Sarmah, D.; Karak, N. Biodegradable superabsorbent hydrogel for water holding in soil and controlled-release fertilizer. J. Appl. Polym. Sci. 2020, 137, 48495. [Google Scholar] [CrossRef]
- Kiani, D.; Borzouei, A.; Ramezanpour, S.; Soltanloo, H.; Saadati, S. Application of gamma irradiation on morphological, biochemical, and molecular aspects of wheat (Triticum aestivum L.) under diferent seed moisture contents. Sci. Rep. 2022, 12, 11082. [Google Scholar] [CrossRef] [PubMed]
- Neethu, T.M.; Dubey, P.K.; Kaswala, A.R. Prospects and Applications of Hydrogel Technology in Agriculture. Int. J. Curr. Microbiol. Appl. Sci. 2018, 7, 3155–3162. [Google Scholar] [CrossRef]
- Xu, H.; Yeum, K.J.; Yoon, Y.H.; Ju, J.H. Effect of Hydrogels in Three Substrates on Growth and Ornamental Quality of Apple Mint (Mentha suaveolens) in Unirrigated Green Roofs. J. Hortic. Sci. 2019, 6, 260. [Google Scholar]
- Luan, L.Q.; Xo, D.H. Preparation of Oligoalginate Immobilized Hydrogel by Radiation and Its Application for Hydroponic Culture. Radioisotopes 2017, 66, 171–179. [Google Scholar] [CrossRef]
- Rollon, R.J.C.; Batac, R.A.; Batac, R.A.; Maglines, S.M. Effects of carbonized rice hull and arbuscular mycorrhizal fungi application on potting media chemical properties, growth and nutrient uptake of Falcata (Paraserianthes falcataria L.). Int. J. Agron. Agric. Res. 2018, 13, 93–101. [Google Scholar]
- Skrzypczak, D.; Mikula, K.; Kossińska, N.; Widera, B.; Warchoł, J.; Moustakas, K. Biodegradable hydrogel materials for water storage in agriculture-review of recent research. Desalin. Water Treat. 2020, 194, 324–332. [Google Scholar] [CrossRef]
- Arya, R.; Chopra, L.; Prishya, A. hydrogels: A revolutionary. Eur. Chem. Bull. 2023, 12, 2871–2885. [Google Scholar]
- Popa, E.E.; Popa, M.E. Use of hydrogels as a sustainable solution for water and nutrients management in plant culture. Sci. Bull. Ser. F. Biotechnol. 2022, 26, 2014–2016. [Google Scholar]
- Abdel Hakiem, A.A.; Abdel Moneam, Y.K.; Said, H.M.; Senna, M.M.H. Radiation induced biodegradable polymer blends for growth promotion of corn plants. Polym. Renew. Resour. 2022, 13, 3–27. [Google Scholar] [CrossRef]
- Sannino, A. Application of Superabsorbent Hydrogels for The Optimization of Water Resources in Agriculture. In Proceedings of the 3rd International Conference on Water Resources and Arid Environments and the 1st Arab Water Forum, Riyadh, Saudi Arabia, 16–19 November 2008; University of Salento: Monteroni, Italy, 2008; p. 1. [Google Scholar]
- Patra, S.K.; Poddar, R.; Brestic, M.; Acharjee, P.U.; Bhattacharya, P.; Sengupta, S. Prospects of Hydrogels in Agriculture for Enhancing Crop and Water Productivity under Water Deficit Condition. Int. J. Polym. Sci. 2022, 2022, 4914836. [Google Scholar] [CrossRef]
- Cock, L.S.; Guancha-Chalapud, M.A. Natural fibers for hydrogels production and their applications in agriculture. Acta Agron. 2017, 66, 495–505. [Google Scholar] [CrossRef]
- Abobatta, W. Impact of hydrogel polymer in agricultural sector. Adv. Agric. Env. Sci. Open Access 2018, 1, 59–64. [Google Scholar] [CrossRef]
- Tariq, Z.; Iqbal, D.N.; Rizwan, M.; Ahmad, M.; Faheem, M.; Ahmed, M. Significance of biopolymer-based hydrogels and their applications in agriculture: A review in perspective of synthesis and their degree of swelling for water holding. RSC Adv. 2023, 13, 24731–24754. [Google Scholar] [CrossRef] [PubMed]
- Saini, A.K.; Malve, S.H. Impact of Hydrogel on Agriculture—A review. Ecol. Environ. Conserv. 2023, 29, 36–47. [Google Scholar] [CrossRef]
- Kratochvílová, R.; Kráčalík, M.; Smilková, M.; Sedláček, P.; Pekař, M.; Bradt, E. Functional Hydrogels for Agricultural Application. Gels 2023, 9, 590. [Google Scholar] [CrossRef] [PubMed]
- Ahmad, D.F.B.A.; Wasli, M.E.; Tan, C.S.Y.; Musa, Z.; Chin, S.F. Eco-friendly cellulose-based hydrogels derived from wastepapers as a controlled-release fertilizer. Chem. Biol. Technol. Agric. 2023, 10, 36. [Google Scholar] [CrossRef]
- Rashidzadeh, A.; Olad, A.; Reyhanitabar, A. Hydrogel/clinoptilolite nanocomposite-coated fertilizer: Swelling, water-retention and slow-release fertilizer properties. Polym. Bull. 2015, 72, 2667–2684. [Google Scholar] [CrossRef]
- Li, Y.; Qin, Y.; Liu, S.; Li, P.; Xing, R. Preparation, characterization, and antifungal activity of hymexazol-linked chitosan derivatives. Chin. J. Oceanol. Limnol. 2017, 35, 1079–1085. [Google Scholar] [CrossRef]

| Synthesis Method | Example | Advantage | Disadvantage | Application in Different Field | Dose Range (KGy) | Ref. |
|---|---|---|---|---|---|---|
| Gama radiation synthesis | Polyethylene glycol diacrylate (PEGDA) | Precise crosslinking | Requires specialized facilities | Biomedical: drug delivery systems, tissue engineering | 10–25 | [54,55] |
| Agriculture: soil conditioning, water retention | ||||||
| Environmental: wastewater treatment | ||||||
| Industrial: smart materials, sensors | ||||||
| Electron beam irradiation | Polyvinyl alcohol (PVA) | Controlled crosslinking | High equipment costs | Biomedical: tissue scaffolds, wound dressings | 10–50 | [56,57] |
| Food Packaging: enhanced barrier properties, extended shelf life | ||||||
| Environmental: pollutant removal, water treatment | ||||||
| Industrial: tailored materials, coatings | ||||||
| UV light irradiation | Poly(N-isopropylacrylamide) (PNIPAM) | Cost-effective | Limited depth penetration | Biomedical: photo responsive hydrogels, drug release systems | N/A | [58,59] |
| Adhesives: quick curing | ||||||
| Coatings: surface modification for bio applications. |
Disclaimer/Publisher’s Note: The statements, opinions and data contained in all publications are solely those of the individual author(s) and contributor(s) and not of MDPI and/or the editor(s). MDPI and/or the editor(s) disclaim responsibility for any injury to people or property resulting from any ideas, methods, instructions or products referred to in the content. |
© 2024 by the authors. Licensee MDPI, Basel, Switzerland. This article is an open access article distributed under the terms and conditions of the Creative Commons Attribution (CC BY) license (https://creativecommons.org/licenses/by/4.0/).
Share and Cite
Ahmed, M.S.; Islam, M.; Hasan, M.K.; Nam, K.-W. A Comprehensive Review of Radiation-Induced Hydrogels: Synthesis, Properties, and Multidimensional Applications. Gels 2024, 10, 381. https://doi.org/10.3390/gels10060381
Ahmed MS, Islam M, Hasan MK, Nam K-W. A Comprehensive Review of Radiation-Induced Hydrogels: Synthesis, Properties, and Multidimensional Applications. Gels. 2024; 10(6):381. https://doi.org/10.3390/gels10060381
Chicago/Turabian StyleAhmed, Md. Shahriar, Mobinul Islam, Md. Kamrul Hasan, and Kyung-Wan Nam. 2024. "A Comprehensive Review of Radiation-Induced Hydrogels: Synthesis, Properties, and Multidimensional Applications" Gels 10, no. 6: 381. https://doi.org/10.3390/gels10060381
APA StyleAhmed, M. S., Islam, M., Hasan, M. K., & Nam, K.-W. (2024). A Comprehensive Review of Radiation-Induced Hydrogels: Synthesis, Properties, and Multidimensional Applications. Gels, 10(6), 381. https://doi.org/10.3390/gels10060381

